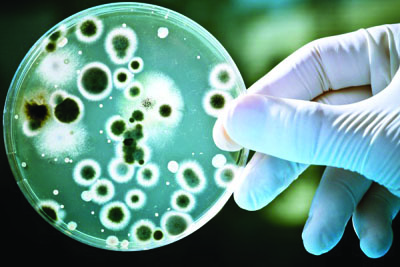
fungi3-600x400

If you’re in EHS Cop mode your job is about to be disrupted! A convergence of technologies is occurring that will have a profound impact on the future of our workplaces as EHS professionals and employees. Today I want to focus on several trends: cloud based Safety Management Software, Learning Management Systems, Optical Object Tracking Systems and Wearable Sensors. I’ll give some detail on each below but the most important point I am making is that these technologies, and likely others to follow, are going to change our profession. You had better be ready for it! Of critical importance to us as practitioners is understanding how to take advantage of the new capabilities and how we add value after they enter the workplace.
These technology tools will shortly be combined and utilized by organizations to obtain further efficiencies regarding time and labor (cost). Each of these tools will automate aspects of our current work tasks. Reporting, Inspecting/Observing and Training will be accomplished by computers. If these are the majority of the activities you are engaged in, you may be redundant. A fourth piece of technology pulls all this together into an easy to use interface. We know the technology as Siri, the iPhone app (further explanation below). Your boss will soon be asking his iPad how many recordables his plant has last year.
Same old story right? Technology makes another type of job obsolete… Not quite. EHS, at it’s core, is about the human condition. The biggest impact on the human condition is, well, humans! Only a human can have a truly meaningful and maximally influential impact on another human. One of the sources from which I have been finding new directions about leading people is from management leadership thought leader Harold Jarche. In a recent blog post titled Some Useful Models, Mr. Jarche made the following thought provoking statement:
Command and control will be replaced by influence and respect, in order to retain creative talent.
A computer, or any other piece of technology, cannot Lead people. Leading is the ability to articulate a vision, enable people to engage in it and create the desire in them to take action to see the vision become reality. In the recently published HBR post Why Good Managers Are So Rare, by Randall Beck and James Harter, the talents of a great Manager are identified. I believe a great manager is a great leader. The traits of such an impactful person are:
- Motivation of employees to take action and engage them with a compelling mission and vision.
- Assertiveness to drive outcomes even with resistance.
- Accountability, for themselves and members of the group.
- Relationships that create trust, open dialogue, and full transparency.
- Making decisions that are based on productivity, not politics.
Note that machines are not capable of displaying the first 4 of these talents. Even their ability to make decisions requires a simple situation with predefined outcomes. It is our ability to connect with each other that has the most power to influence the human condition. Leaders find ways to engage those they lead in order to create an environment were all can participate. This inclusion drives motivation perform actions that achieve the group’s shared goals.
In the final analysis, the coming convergence of technologies will be a boon for our profession and the stakeholders we serve. It will allow an unprecidented level of focus on solutions that result in significant improvement in people’s lives, environmental protection and business sustainability. These systems will allow us to spend less time collecting, organizing and turning data into information, and more time accomplishing improvements and motivating people. To be successful in the work environment equipped with this new technology, we must be in leadership mode. It’s our ability to connect with, influence and provide vision for people that is the real value of what we do – with or without technology.
Deeper Dive on Technology
Safety Management Software (Decision Support Systems) are interactive software-based systems intended to help decision makers compile useful information from a combination of raw data, documents, and personal knowledge, or business models to identify and solve problems and make decisions. An example from the EHS function is the VelocityEHS or GenSuite programs for EHS. These systems act as data collections, warehousing and querying capabilities that allow users to make sense out of the data being produced by the EHS Processes of the organization. In short, these systems take raw data and provide detailed and specific information needed to make informed decisions. (4/30/19 update): This industry continues to innovate and grow. A helpful reference for implementing safety management software is available from NAEM: The 2017 EHS & Sustainability Software Buyer’s Guide
Learning Management Systems are software applications for the administration, documentation, tracking, reporting and delivery of e-learning education courses or training programs. They allow personnel in the work environment to take the courses at the time and pace that fits their schedule. They are fully automated systems that require only the student to present during the instruction. The current trend is the blending of the DSS and LMS systems, such as the PureSafety example above.
Optical Object Tracking software can track objects in pace and real time and identify and record what actions those objects are performing. The technology originated in the missile defense industry but was quickly repurposed for tracking player actions in sporting events. The NBA has become particularly interested in this technology. The video clip below demonstrates the program in operation for a basketball game.
The software as applied to sports uses layers of software to track the objects, record the their actions, classify the actions and convert the raw data into information. The information is in the form of statistics. An Israeli company called SportVu is the developer of this technology.
Wearable Sensors (Authors Note 4/30/19: this is an update to the original post) In the last five years sensor technology has become much smaller and powerful. As of early 2019, the market for wearable sensors used for tracking human movement and bio metrics continues to grow rapidly. Current products are offered that track such human conditions as body segment position/movement/physical stress, biometrics such as pulse, respiration, sleep quality, and mental states such as stress and cognitive load. Also in the category of wearables are exoskeletons intended to prevent human injury. Exoskeleton technology is rapidly advancing today but is still in what I would consider the “beta test” phase. Ford Motor Company is doing some in-depth evaluation of Exoskeletons. The segment below from The Verge summarizes it nicely.
Johns Hopkins recently published a nice discussion of the wearables topic related to public health: 5 ways mobile sensors are changing public health.
Siri of the Future: a “Do Engine”. The effort to create an artificially intelligent electronic personal assistant has been underway for some time. The software Siri is composed of is already far more powerful that we realize. Siri like systems will evolve into Do engines. Do Engines are search engines that are capable of completing tasks in the physical environment. An example would be you telling future Siri to find the most protective hard hat at the cheapest price and order 10 for deliver to the office in one week.
Technology, Privacy and Ethics (Authors Note 4/30/19: this is an update to the original post)
This is not a new area of concern. Recent events in 2018 and 2019 have brought the subject of privacy to the forefront of discussion. Privacy from technologies is of paramount importance to all free societies and their citizens. I recently came across some work NIOSH did in early 2018 on the subject of ethical use of new technologies in the work environment: Wearable Sensors: An Ethical Framework for Decision-Making. They are making the case that central considerations in the use of a technology impacting personal privacy should center around the benefit to society and the minimization of harm to individuals. The case law is still fleshing out he particulars on this subject and will be for years to come (See: ACLU: The Supreme Court’s Groundbreaking Privacy Victory for the Digital Age) I suggest however that following NIOSH’s thoughts will provide an ethical and responsible path forward.
Re-Primer on Innovative Disruption
A while back I posted on disruptive innovation. I believe it is important that EHS&S professionals understand what effect market disruption has on the organizations we serve. If you are not familiar with the term take a quick look at my post.